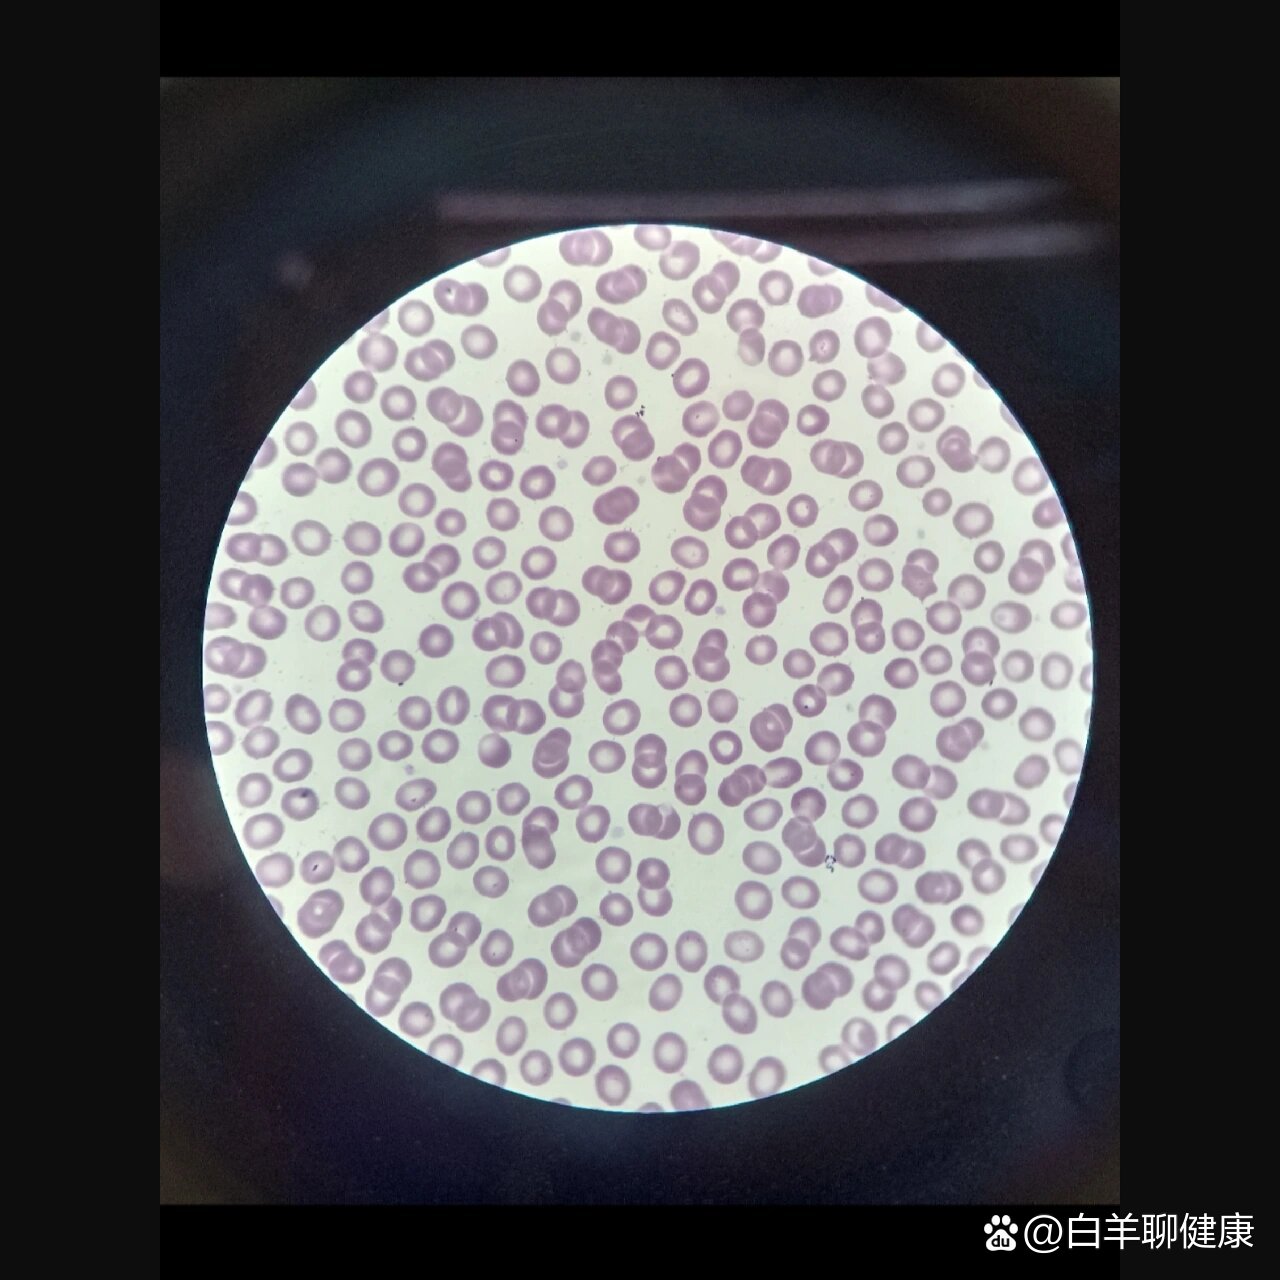
一些红细胞和白细胞

白细胞简笔画红细胞

血细胞涂片绘画
图片尺寸1440x2560
细胞微观世界🔬点绘微观之美
图片尺寸1080x1358
绘制蛙血细胞内核酸分布图
图片尺寸1920x1540 图片尺寸2000x1200
图片尺寸2000x1200
红系,粒系细胞手绘图及其特点
图片尺寸1002x968
5x20倍图 3️⃣血细胞10x40倍图 需要参考的自
图片尺寸1080x1362
血细胞手绘图
图片尺寸1280x1706
吞噬细胞吞噬鸡血红细胞
图片尺寸1280x1706
今天简单画一个白细胞.今天是元旦节.祝大家元旦节快乐!
图片尺寸720x1280
白血细胞,矢量, 卡通白色背景上的白色血液细胞
图片尺寸1024x1024
吞噬细胞吞噬鸡血红细胞
图片尺寸1280x1706
一些红细胞和白细胞
图片尺寸1280x1280
蓝色,玫红色,但在心里应该有一个完整的细胞结构图,这画一遍妥妥的又
图片尺寸1080x1410
白色图形填充下图颜色,深于椭圆部分,这样就表现出血红细胞
图片尺寸1280x589
5 血液:白细胞5分类
图片尺寸1370x915
白细胞《工作细胞》 ip简介: 中文名:白细胞 外文名
图片尺寸1080x1350
💉白细胞手绘图片大揭秘🎨
图片尺寸1080x1410
🧬细胞结构手绘简图大揭秘🔍
图片尺寸1080x1438
红蓝铅笔手绘检验人实验课画的各个系各个阶段
图片尺寸1280x1280
白细胞正常形态绘图
图片尺寸1920x2560


 图片尺寸2000x1200
图片尺寸2000x1200

















 图片尺寸2000x1200
图片尺寸2000x1200